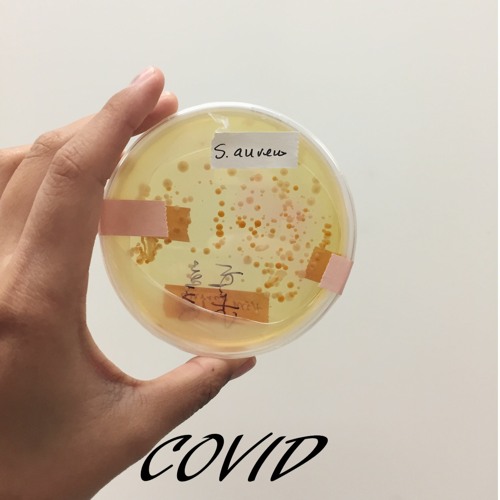
Yor Sholwam

Recent comments
Yessah ReWelya
· 2ySaril peigital resa galifa yar saril falalop😭😍🔥
Mykl Hagil
· 4yPeigital does not have covid 19 but china lol haha bro nice …
yanger
· 4yila ila sengal go taremwanel peigital
j
· 4yIm dead did you say sar mar dalipebnaw 😂









